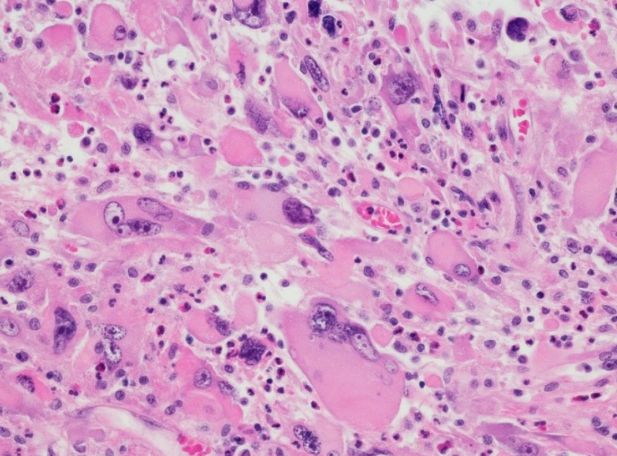

德克萨斯大学 MD 安德森癌症中心的研究人员证明,抗 PD-L1免疫疗法与突变导向靶向疗法相结合可延长未分化甲状腺癌 (ATC)患者的总体生存期 (OS) 。这项 II 期单中心研究的结果今天发表在《JAMA Oncology》上。
该试验招募了 3 个队列中的 42 名患者,以评估突变匹配的靶向治疗和免疫检查点抑制剂阿特珠单抗。所有队列的中位 OS 为 19 个月,与 ATC 患者过去 5 个月的 OS 相比更为有利。队列中 BRAFV600E 突变患者的最长 OS 为 43.2 个月 - 这是迄今为止公布的 ATC 系统治疗的最长 OS。
“患有未分化甲状腺癌的患者需要快速起效的治疗,我们看到这种联合治疗方法取得了令人鼓舞的结果。这项研究的结论是,免疫疗法确实为患者带来了益处,”首席研究员、内分泌肿瘤和激素紊乱教授Maria Cabanillas 医学博士说。“基于这些发现,我们目前在 将此组合作为 ATC 和 BRAF 突变患者的标准治疗方法。”
未分化甲状腺癌是一种罕见且高度侵袭性的恶性肿瘤,预后极差。未分化甲状腺癌通常由分化型甲状腺癌亚型发展而来,例如乳头状甲状腺癌和滤泡状甲状腺癌,每种亚型都有不同的驱动突变,可影响肿瘤行为和进展。
BRAF 基因突变具有治疗和预后意义,40% 的甲状腺癌患者会出现这种突变。该试验招募了 18 名 BRAF 突变的 ATC 患者,作为第 1 组患者,他们接受了阿替利珠单抗加维莫非尼和考比替尼靶向治疗组合的治疗。中位 OS 为 43.2 个月,客观缓解率 (ORR) 为 50%。
第 2 组招募了 21 名患有 RAS(NRAS、KRAS 或 HRAS)或 NF1/2 突变的患者,接受 cobimetinib 加 atezolizumab 治疗。该组合实现了 8.7 个月的中位 OS 和 14% 的 ORR。
队列 3 包括 3 名未出现上述任何突变的 ATC 患者,他们接受了贝伐单抗加阿特珠单抗治疗。中位 OS 为 6.21 个月,ORR 为 33%。
Cabanillas 解释道,这项试验之所以引人注目,还因为从历史上看,临床试验很难招募 ATC 患者。这项研究的入选标准更为宽松,因此在四年内成功招募了 42 名患者。例如,考虑到病情可能迅速恶化,试验允许患者在筛选期间继续接受化疗。此外,该研究允许患者使用替代配方通过饲管服用口服药物。
研究人员观察到了这些药物的副作用,这些副作用与之前试验中预期的一致。所有患者最常见的不良反应包括疲劳、淋巴细胞减少、腹泻和贫血。少数患者出现了明显的严重副作用,包括结肠和食道穿孔。
Cabanillas 表示:“目前尚无针对非 BRAF 突变 ATC 的有效疗法,我们将继续专注于该领域的研究。我们正在努力优化患者的治疗效果。我们希望他们能够活得更长、更好,这项研究为 ATC 患者带来了希望。”
本研究的局限性包括缺乏对照组,这在罕见肿瘤试验中是一个挑战,以及接受放射治疗和手术切除原发肿瘤,这可能有助于提高生存率。然而,研究人员认为,未来的 ATC 临床试验应该设计为允许手术,因为这可能有助于提高本研究中的生存率。
这项研究得到了 Genentech、MD Anderson 罕见肿瘤计划(该机构战略研究计划发展 (STRIDE) 计划的一部分)以及美国国立卫生研究院 (CA016672) 的支持。